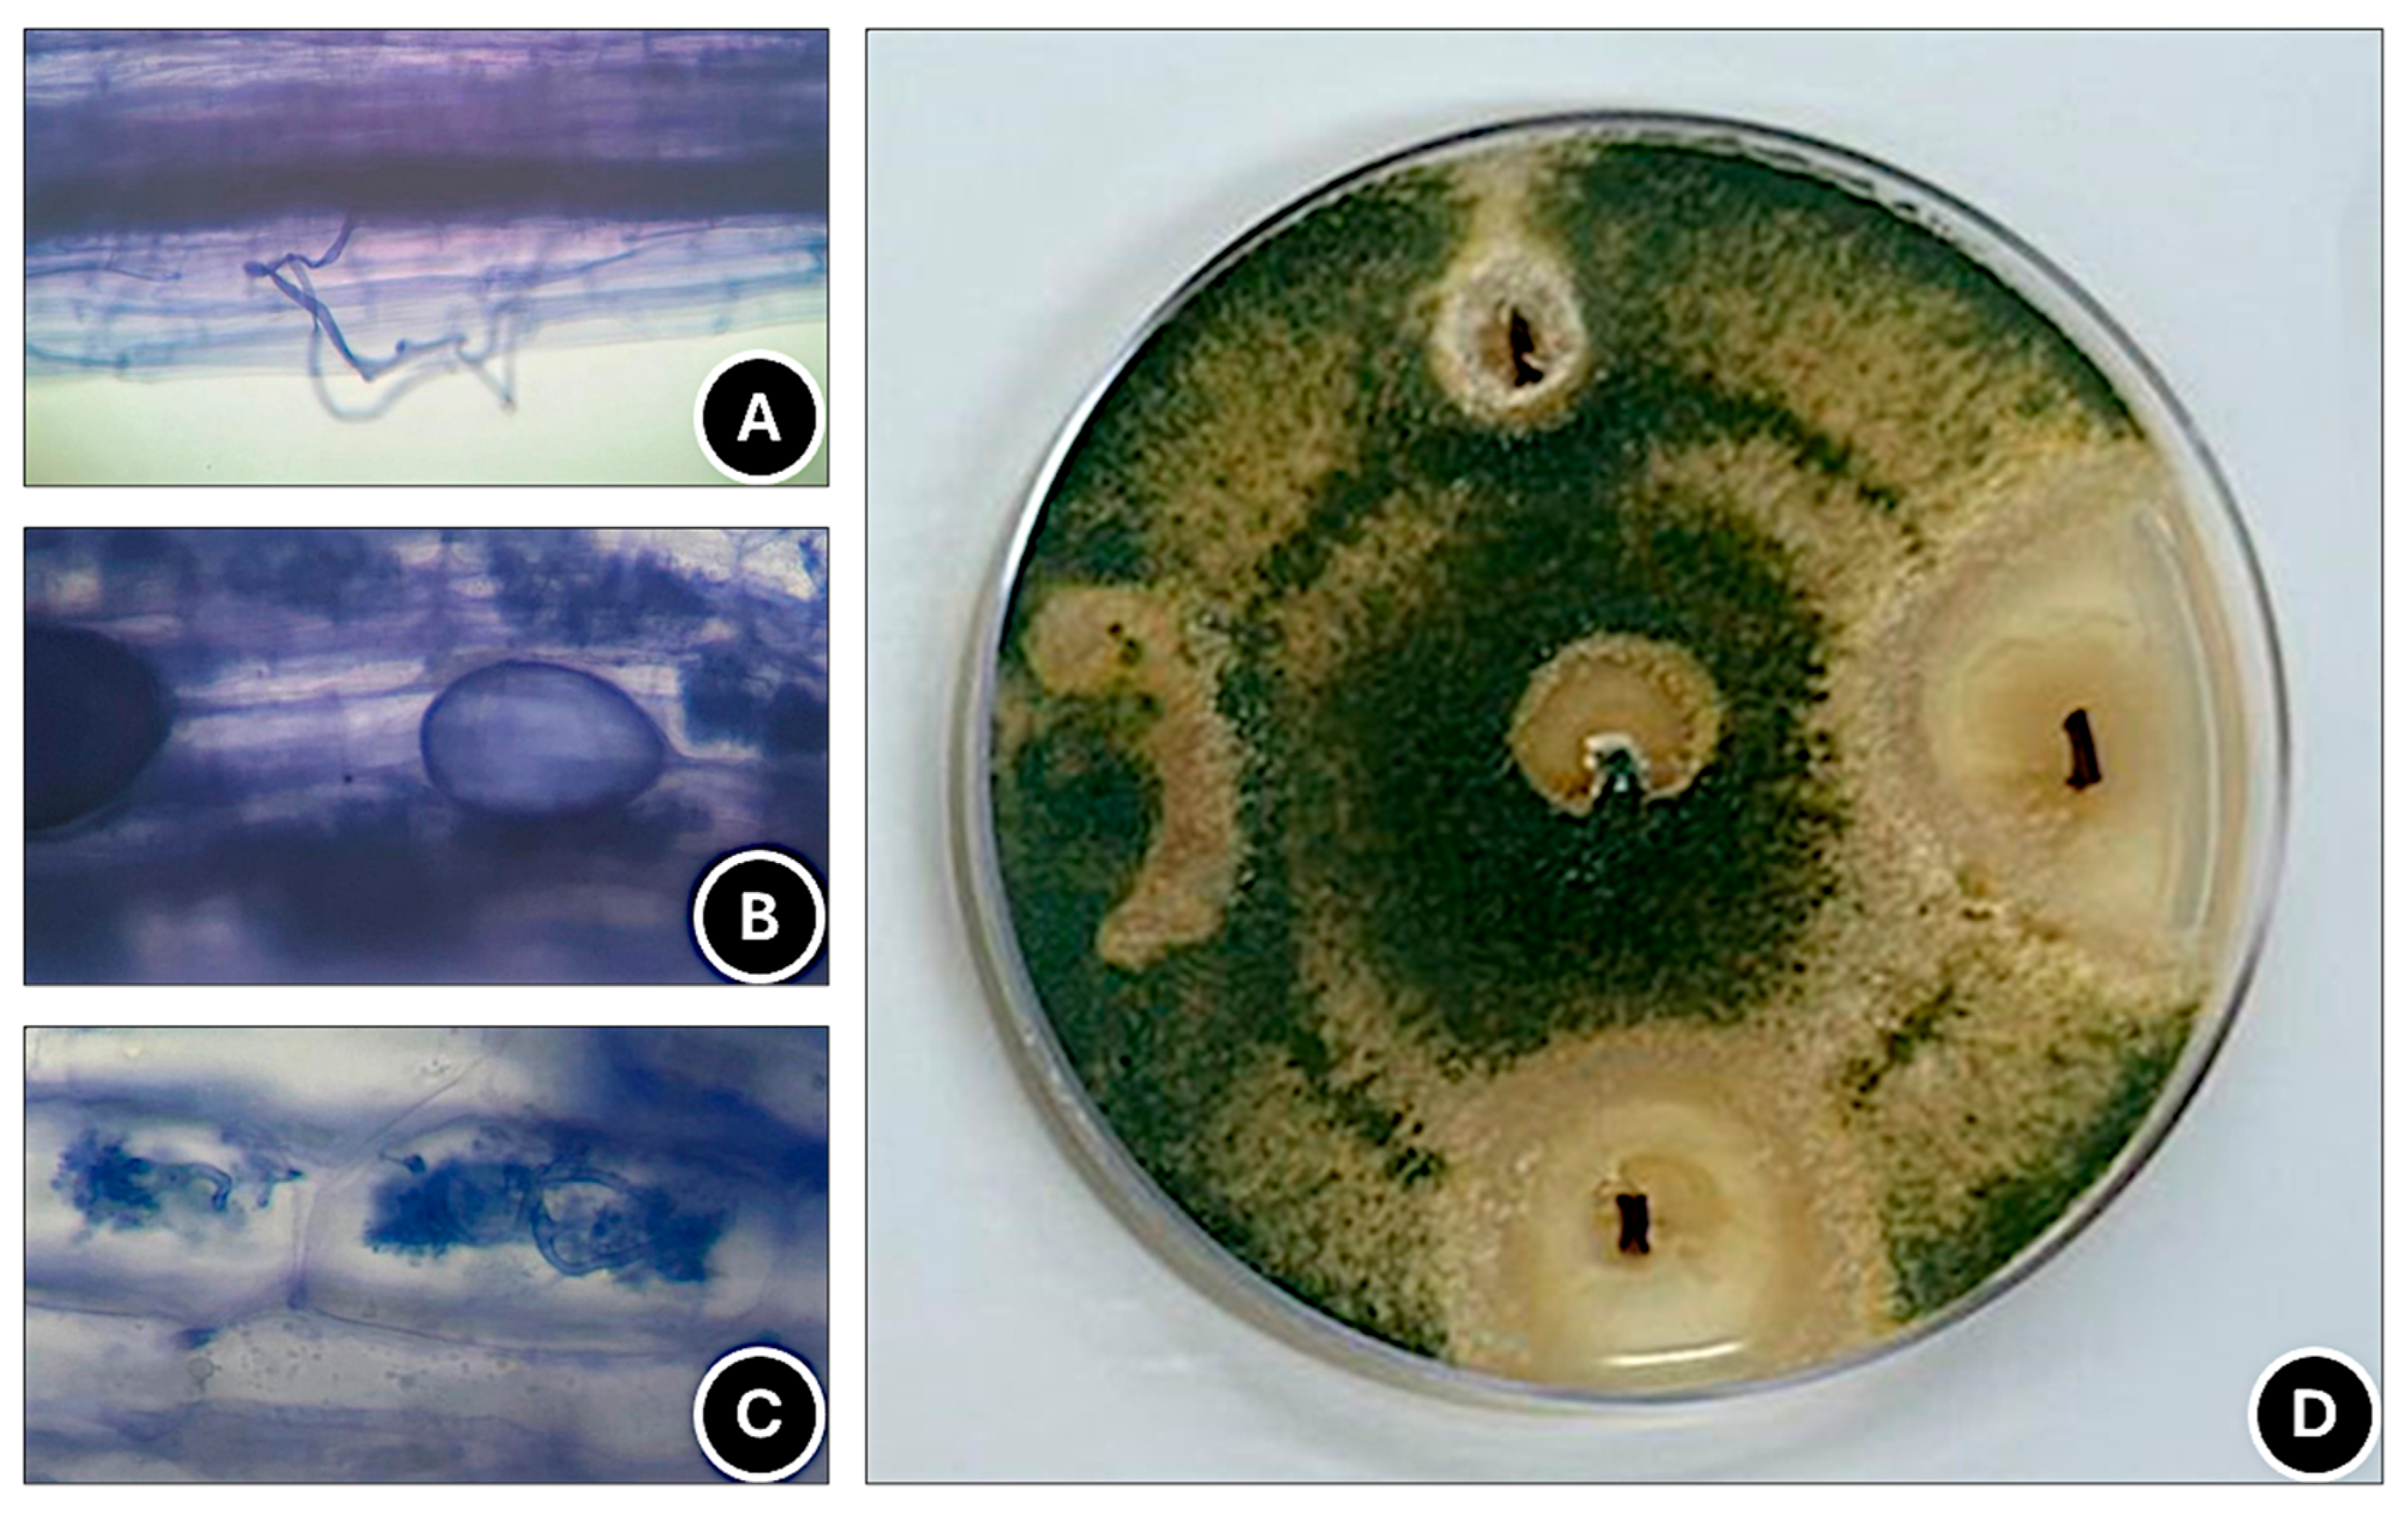
Horticulturae 12 00056 g004 Horticulturae 12 00056 g004

Microbial Biostimulants and Their Combinations Alter Phytochemical Quality of Strawberry Fruits in a Soilless Cultivation System
Abstract
1. Introduction
2. Materials and Methods
2.1. Plant Material
2.2. Experimental Design
2.3. On-Farm Production of Mycorrhizal Inoculants
2.4. Cultivation Techniques
2.5. Detection of AMF and T. harzianum in Roots
2.6. Fruit Yield
2.7. Fruit Quality
2.8. Data Analysis
3. Results
3.1. Detection of AMF and T. harzianum in Roots
3.2. Fruit Yield
3.3. Fruit Quality
3.4. Multivariate Analysis
4. Discussion
5. Conclusions
Author Contributions
Funding
Data Availability Statement
Acknowledgments
Conflicts of Interest
References
- Chiomento, J.L.T.; De Nardi, F.S.; Fante, R.; Dal Pizzol, E.; Trentin, T.S.; Borba, A.C.; Basílio, L.S.P.; Garcia, V.A.S.; Lima, G.P.P. Building the microbiota in strawberry soilless cultivation systems with on-farm AMF inoculants: Roles in yield, phytochemical profile, and root morphology. S. Afr. J. Bot. 2025, 178, 226–234. [Google Scholar] [CrossRef]
- Chiomento, J.L.T.; Fracaro, J.; Görgen, M.; Fante, R.; Dal Pizzol, E.; Welter, M.; Klein, A.P.; Trentin, T.S.; Suzana-Milan, C.S.; Palencia, P. Arbuscular mycorrhizal fungi, Ascophyllum nodosum, Trichoderma harzianum, and their combinations influence the phyllochron, phenology, and fruit quality of strawberry plants. Agronomy 2024, 14, 860. [Google Scholar] [CrossRef]
- Drobek, M.; Cybulska, J.; Frąc, M.; Pieczywek, P.; Pertile, G.; Chibrikov, V.; Nosalewicz, A.; Feledyn-Szewczyk, B.; Sas-Paszt, L.; Zdunek, A. Microbial biostimulants affect the development of pathogenic microorganisms and the quality of fresh strawberries (Fragaria ananassa Duch.). Sci. Hortic. 2024, 327, 112793. [Google Scholar] [CrossRef]
- Díaz-Rodríguez, A.M.; Parra Cota, F.I.; Cira Chávez, L.A.; García Ortega, L.F.; Estrada Alvarado, M.I.; Santoyo, G.; De Los Santos-Villalobos, S. Microbial inoculants in sustainable agriculture: Advancements, challenges, and future directions. Plants 2025, 14, 191. [Google Scholar] [CrossRef] [PubMed]
- Castillo-Girones, S.; Ruizendaal, J.; Salas-Valderrama, X.; Munera, S.; Blasco, J.; Polder, G. Advanced evaluation of strawberry quality, consumer preference, and cultivar discrimination through spectral imaging and neural networks. Food Control 2025, 175, 111339. [Google Scholar] [CrossRef]
- Trentin, T.S.; Dornelles, A.G.; Trentin, N.S.; Huzar-Novakowiski, J.; Calvete, E.O.; Chiomento, J.L.T. Addition of arbuscular mycorrhizal fungi and biochar in the cultivation substrate benefits macronutrient contents in strawberry plants. J. Soil Sci. Plant Nutr. 2022, 22, 2980–2991. [Google Scholar] [CrossRef]
- Shirdel, M.; Eshghi, S.; Shahsavandi, F.; Fallahi, E. Arbuscular mycorrhiza inoculation mitigates the adverse effects of heat stress on yield and physiological responses in strawberry plants. Plant Physiol. Biochem. 2025, 221, 109629. [Google Scholar] [CrossRef] [PubMed]
- Whyle, R.L.; Trowbridge, A.M.; Jamieson, M.A. Genotype, mycorrhizae, and herbivory interact to shape strawberry plant functional traits. Front. Plant Sci. 2022, 13, 964941. [Google Scholar] [CrossRef]
- De Nardi, F.S.; Trentin, T.S.; Trentin, N.S.; Costa, R.C.; Calvete, E.O.; Palencia, P.; Chiomento, J.L.T. Mycorrhizal biotechnology reduce phosphorus in the nutrient solution of strawberry soilless cultivation systems. Agronomy 2024, 14, 355. [Google Scholar] [CrossRef]
- Lombardi, N.; Caira, S.; Troise, A.D.; Scaloni, A.; Vitaglione, P.; Vinale, F.; Marra, R.; Salzano, A.M.; Lorito, M.; Woo, S.L. Trichoderma applications on strawberry plants modulate the physiological processes positively affecting fruit production and quality. Front. Microbiol. 2020, 11, 1364. [Google Scholar] [CrossRef]
- Massoud, M.A.; Kordy, A.M.; Abdel-Mageed, A.A.; Heflish, A.I.A.; Sehier, M.M. Impact of chitosan, Trichoderma harzianum, thyme oil and jojoba extract against Fusarium wilt disease of strawberry. J. Adv. Agric. Res. 2020, 25, 176–196. [Google Scholar] [CrossRef]
- Chiomento, J.L.T.; Stürmer, S.L.; Carrenho, R.; Costa, R.C.; Scheffer-Basso, S.M.; Antunes, L.E.C.; Nienow, A.A.; Calvete, E.O. Composition of arbuscular mycorrhizal fungi communities signals generalist species in soils cultivated with strawberry. Sci. Hortic. 2019, 253, 286–294. [Google Scholar] [CrossRef]
- Redecker, D.; Schubler, A.; Stockinger, H.; Stürmer, S.L.; Morton, J.B.; Walker, C. An evidence based consensus for the classification of arbuscular mycorrhizal fungi (Glomeromycota). Mycorrhiza 2013, 23, 515–531. [Google Scholar] [CrossRef]
- Stutz, J.C.; Morton, J.B. Successive pot culture reaveal high species richness of arbuscular endomycorrhizal fungi in arid ecosystems. Can. J. Bot. 1996, 74, 1883–1889. [Google Scholar] [CrossRef]
- Phillips, J.M.; Hayman, D.S. Improved procedures for clearing roots and staining parasitic and vesicular-arbuscular mycorrhizal fungi for rapid assessment of infection. Trans. Br. Mycol. Soc. 1970, 55, 158–161. [Google Scholar] [CrossRef]
- Trouvelot, A.; Kouch, J.; Gianinazzi-Pearson, V. Mesure du taux de mycorhization VA d’un système radiculaire: Recherche of method d’estimation ayant une signification fonctionelle. In Aspects Physiologiques et Génétiques des Mycorhizes; Gianinazzi-Pearson, V., Gianinazzi, S., Eds.; Inra Press: Paris, France, 1986; pp. 217–221. [Google Scholar]
- Zenebon, O.; Pascuet, N.S.; Tiglea, P. Métodos Físico-Químicos para Análise de Alimentos, 4th ed.; Instituto Adolfo Lutz: São Paulo, Brasil, 2008; p. 1020. [Google Scholar]
- Giusti, M.M.; Wrolstad, R.E. Anthocyanins: Characterization and measurement with UV-visible spectroscopy. In Current Protocols in Food Analytical Chemistry; Wrolstad, R.E., Ed.; John Wiley & Sons: New York, NY, USA, 2001; pp. 1–13. [Google Scholar]
- Basílio, L.S.P.; Borges, C.V.; Minatel, I.O.; Vargas, P.F.; Tecchio, M.A.; Vianello, F.; Lima, G.P.P. New beverage based on grapes and purple-fleshed sweet potatoes: Use of non-standard tubers. Food Biosci. 2022, 47, 101626. [Google Scholar] [CrossRef]
- Singleton, V.L.; Rossi, J.A. Colorimetry of total phenolics with phosphomolybidic-phosphotungstic acid reagent. Am. J. Enol. Vitic. 1965, 16, 144–158. [Google Scholar] [CrossRef]
- R Core Team. R: A Language and Environment for Statistical Computing; R Foundation for Statistical Computing: Vienna, Austria, 2025. [Google Scholar]
- Kaiser, H.F. The varimax criterion for analytic rotation in factor analysis. Psychometrika 1958, 23, 187–200. [Google Scholar] [CrossRef]
- Sokal, R.R.; Rohlf, F.J. The comparison of dendrograms by objective methods. Taxon 1962, 11, 33–40. [Google Scholar] [CrossRef]
- Reino, J.L.; Guerrero, R.F.; Hernández-Galán, R.; Collado, I.G. Secondary metabolites from species of the biocontrol agent Trichoderma. Phytochem. Rev. 2008, 7, 89–123. [Google Scholar] [CrossRef]
- Contreras-Cornejo, H.A.; Schmoll, M.; Esquivel-Ayala, B.A.; González-Esquivel, C.E.; Rocha-Ramírez, V.; Larsen, J. Mechanisms for plant growth promotion activated by Trichoderma in natural and managed terrestrial ecosystems. Microbiol. Res. 2024, 281, 127621. [Google Scholar] [CrossRef]
- Guzmán-Guzmán, P.; Etesami, H.; Santoyo, G. Trichoderma: A multifunctional agent in plant health and microbiome interactions. BMC Microbiol. 2025, 25, 434. [Google Scholar] [CrossRef]
- Covacevich, F.; Fernandez-Gnecco, G.; Consolo, V.F.; Burges, P.L.; Calo, G.F.; Mondino, E.A. Combined soil inoculation with mycorrhizae and Trichoderma alleviates nematode-induced decline in mycorrhizal diversity. Diversity 2025, 17, 334. [Google Scholar] [CrossRef]
- Vázquez, M.M.; César, S.; Azcón, R.; Barea, J.M. Interactions between arbuscular mycorrhizal fungi and other microbial inoculants (Azospirillum, Pseudomonas, Trichoderma) and their effects on microbial population and enzyme activities in the rhizosphere of maize plants. Appl. Soil Ecol. 2000, 15, 261–272. [Google Scholar] [CrossRef]
- Martínez-Medina, A.; Roldán, A.; Albacete, A.; Pascual, J.A. The interaction with arbuscular mycorrhizal fungi or Trichoderma harzianum alters the shoot hormonal profile in melon plants. Phytochemistry 2011, 72, 223–229. [Google Scholar] [CrossRef] [PubMed]
- Yuan, S.; Li, M.; Fang, Z.; Liu, Y.; Shi, W.; Pan, B.; Wu, K.; Shi, J.; Shen, B.; Shen, Q. Biological control of tobacco bacterial wilt using Trichoderma harzianum amended bioorganic fertilizer and the arbuscular mycorrhizal fungi Glomus mosseae. Biol. Control 2016, 92, 164–171. [Google Scholar] [CrossRef]
- Israel, A.; Langrand, J.; Fontaine, J.; Sahraoui, A.L.H. Significance of arbuscular mycorrhizal fungi in mitigating abiotic environmental stress in medicinal and aromatic plants: A review. Foods 2022, 11, 2591. [Google Scholar] [CrossRef]
- Yang, R.; Qin, Z.; Wang, J.; Zhang, X.; Xu, S.; Zhao, W.; Huang, Z. The interactions between arbuscular mycorrhizal fungi and Trichoderma longibrachiatum enhance maize growth and modulate root metabolome under increasing soil salinity. Microorganisms 2022, 10, 1042. [Google Scholar] [CrossRef] [PubMed]
- Zhao, Y.; Cartabia, A.; Lalaymia, I.; Declerck, S. Arbuscular mycorrhizal fungi and production of secondary metabolites in medicinal plants. Mycorrhiza 2022, 32, 221–256. [Google Scholar] [CrossRef]
- Battaglia, M.E.; Martinez, S.I.; Covacevich, F.; Consolo, V.F. Trichoderma harzianum enhances root biomass production and promotes lateral root growth of soybean and common bean under drought stress. Ann. Appl. Biol. 2024, 185, 36–48. [Google Scholar] [CrossRef]
- Smith, S.E.; Smith, F.A. Roles of arbuscular mycorrhizas in plant nutrition and growth: New paradigms from cellular to ecosystem scales. Annu. Rev. Plant Biol. 2011, 62, 227–250. [Google Scholar] [CrossRef] [PubMed]
- Eftekhari, F.; Sarcheshmehpour, M.; Lohrasbi-Nejad, A.; Boroomand, N. Effects of mycorrhizal and Trichoderma treatment on enhancing maize tolerance to salinity and drought stress, through metabolic and enzymatic evaluation. BMC Plant Biol. 2025, 25, 687. [Google Scholar] [CrossRef]
- Szczałba, M.; Kopta, T.; Gastoł, M.; Sękara, A. Comprehensive insight into arbuscular mycorrhizal fungi, Trichoderma spp. and plant multilevel interactions with emphasis on biostimulation of horticultural crops. J. Appl. Microbiol. 2019, 127, 630–647. [Google Scholar] [CrossRef] [PubMed]
- George, N.P.; Ray, J.G. The inevitability of arbuscular mycorrhiza for sustainability in organic agriculture—A critical review. Front. Sustain. Food Syst. 2023, 7, 1124688. [Google Scholar] [CrossRef]
- Rosling, A.; Eshghi-Sahraei, S.; Kalsoom-Khan, F.; Desirò, A.; Bryson, A.E.; Mondo, S.J.; Grigoriev, I.V.; Bonito, G.; Sánchez-García, M. Evolutionary history of arbuscular mycorrhizal fungi and genomic signatures of obligate symbiosis. BMC Genom. 2024, 25, 529. [Google Scholar] [CrossRef] [PubMed]
- Bitterlich, M.; Rouphael, Y.; Graefe, J.; Franken, P. Arbuscular mycorrhizas: A promising component of plant production systems provided favorable conditions for their growth. Front. Plant Sci. 2018, 9, 1329. [Google Scholar] [CrossRef]
- Pedersen, A.C.; De Nardi, F.S.; Costa, R.C.; Antoniolli, R.; Stürmer, S.L.; Calvete, E.O. Diversity of arbuscular mycorrhizal fungi in strawberry crop systems detected in trap cultures. Acta Hortic. 2017, 1170, 1085–1092. [Google Scholar] [CrossRef]
- Weber, S.E.; Bascompte, J.; Kahmen, A.; Niklaus, P.A. Plant choice between arbuscular mycorrhizal fungal species results in increased plant P acquisition. PLoS ONE 2024, 19, 0292811. [Google Scholar] [CrossRef]
- Chiomento, J.L.T.; De Paula, J.E.C.; De Nardi, F.S.; Trentin, T.S.; Magro, F.B.; Dornelles, A.G.; Anzolin, J.; Fornari, M.; Trentin, N.S.; Rizzo, L.H.; et al. Arbuscular mycorrhizal fungi influence the horticultural performance of strawberry cultivars. Res. Soc. Dev. 2021, 10, 45410716972. [Google Scholar] [CrossRef]
- Lúcio, A.D.C.; Calvete, E.O.; De Nardi, F.S.; Lambrecht, D.M.; Engers, L.B.O.; Chiomento, J.L.T. Multivariate relationships in strawberry cultivated with native communities of arbuscular mycorrhizal fungi. Acta Sci. Agron. 2025, 47, 70712. [Google Scholar] [CrossRef]
- Zhang, J.; Diao, F.; Hao, B.; Xu, L.; Jia, B.; Hou, Y.; Ding, S.; Guo, W. Multiomics reveals Claroideoglomus etunicatum regulates plant hormone signal transduction, photosynthesis and La compartmentalization in maize to promote growth under La stress. Ecotoxicol. Environ. Saf. 2023, 262, 115128. [Google Scholar] [CrossRef]
- Smith, S.E.; Read, D.J. Mycorrhizal Symbiosis, 3rd ed.; Academic Press: London, UK, 2008; p. 1377. [Google Scholar]
- Ahmed, N.; Li, J.; Li, Y.; Deng, L.; Deng, L.; Chachar, M.; Chachar, Z.; Chachar, S.; Hayat, F.; Raza, A.; et al. Symbiotic synergy: How arbuscular mycorrhizal fungi enhance nutrient uptake, stress tolerance, and soil health through molecular mechanisms and hormonal regulation. IMA Fungus 2025, 16, 144989. [Google Scholar] [CrossRef]
- Marrassini, V.; Ercoli, L.; Paredes, A.V.A.; Pellegrino, E. Positive response to inoculation with indigenous arbuscular mycorrhizal fungi as modulated by barley genotype. Agron. Sustain. Dev. 2025, 45, 21. [Google Scholar] [CrossRef]
- Ijdo, M.; Cranenbrouch, S.; Declerck, S. Methods for large-scale production of AM fungi: Past, present, and future. Mycorrhiza 2011, 21, 1–16. [Google Scholar] [CrossRef] [PubMed]
- Fornari, M.; Pinzon, E.D.S.; Albrecht, G.E.; Deggerone, Y.S.; Trentin, T.S.; Chiomento, J.L.T. On-farm inoculants based on arbuscular mycorrhizal fungi on wheat performance. Pesqui. Agropecuária Bras. 2024, 59, 03662. [Google Scholar] [CrossRef]
- Nadieline, C.V.; le Quéré, A.; Ndiaye, C.; Diène, A.A.; Do Rego, F.; Sadio, O.; Thioye, Y.I.; Neyra, M.; Mouhamed, C.; Kébé, F.; et al. Development of on-farm AMF inoculum production for sustainable agriculture in Senegal. PLoS ONE 2024, 19, 0310065. [Google Scholar] [CrossRef] [PubMed]

| Physical characterization 1 | ||||||
|---|---|---|---|---|---|---|
| D | TP | AE | RAW | BW | RW | |
| (kg.m−3) | (m3.m−3) | |||||
| 212 | 0.885 | 0.502 | 0.144 | 0.017 | 0.222 | |
| Chemical characterization 2 | ||||||
| N | P2O5 | K2O | OC | pH | EC | C/N ratio |
| % (m.m−1) | mS.cm−1 | |||||
| 0.82 | 0.58 | <0.25 | 26.10 | 5.6 | 1.05 | 33.42 |
| Biostimulants 1 | MC 2 (%) | THI (%) |
|---|---|---|
| Control | 0.0 ± 0.0 c | 0.0 ± 0.0 c |
| TH | 0.0 ± 0.0 c | 68.0 ± 1.47 a |
| CE | 67.5 ± 2.86 a | 0.0 ± 0.0 c |
| IP CS | 50.0 ± 2.09 b | 0.0 ± 0.0 c |
| TH + CE | 57.5 ± 1.83 b | 35.0 ± 1.02 b |
| TH + IP CS | 55.0 ± 1.05 b | 37.0 ± 1.38 b |
| Significance | ** | ** |
| Mean | 38.33 | 23.33 |
| CV 3 (%) | 15.31 | 12.93 |
| Biostimulants 1 | TNF 2 (Number per Plant) | TP (g per Plant) | AFFM (g) |
|---|---|---|---|
| Control | 40.75 ± 0.78 a | 521.27 ± 20.94 a | 12.78 ± 0.85 a |
| TH | 43.54 ± 1.09 a | 576.20 ± 29.85 a | 13.25 ± 1.04 a |
| CE | 39.58 ± 0.94 a | 530.34 ± 38.85 a | 13.40 ± 1.64 a |
| IP CS | 44.87 ± 1.37 a | 557.55 ± 29.05 a | 12.47 ± 0.73 a |
| TH + CE | 41.91 ± 1.46 a | 567.80 ± 41.08 a | 13.53 ± 0.94 a |
| TH + IP CS | 43.87 ± 0.98 a | 575.63 ± 31.23 a | 13.14 ± 1.01 a |
| Significance | NS | NS | NS |
| Mean | 42.42 | 554.80 | 13.09 |
| CV 3 (%) | 11.37 | 10.05 | 6.19 |
| Biostimulants 1 | TSS 2 (%) | TSS/TTA Ratio | TA (mg PE/100 g FF−1) | TF (mg RE/100 g FF−1) | TPO (mg GAE/100 g FF−1) |
|---|---|---|---|---|---|
| Control | 5.02 ± 0.32 b | 5.80 ± 0.00 b | 3.14 ± 0.11 b | 72.93 ± 3.48 c | 886.67 ± 28.95 b |
| TH | 6.30 ± 0.41 ab | 7.02 ± 0.00 ab | 4.72 ± 0.28 ab | 111.34 ± 6.31 b | 1424.12 ± 56.83 a |
| CE | 7.02 ± 0.64 a | 8.42 ± 0.00 a | 4.71 ± 0.15 ab | 113.57 ± 5.97 b | 1307.94 ± 75.92 a |
| IP CS | 5.75 ± 0.87 ab | 7.19 ± 0.00 ab | 5.18 ± 0.36 a | 124.71 ± 5.83 a | 1349.76 ± 69.04 a |
| TH + CE | 5.60 ± 0.93 ab | 7.27 ± 0.00 ab | 5.07 ± 0.27 ab | 123.51 ± 6.27 a | 1363.71 ± 58.15 a |
| TH + IP CS | 5.55 ± 0.31 ab | 7.20 ± 0.00 ab | 5.04 ± 0.10 ab | 121.21 ± 7.04 a | 1570.51 ± 79.21 a |
| Significance | ** | ** | ** | ** | ** |
| Mean | 5.94 | 7.15 | 4.64 | 111.21 | 1317.12 |
| CV 3 (%) | 10.63 | 11.97 | 11.22 | 10.43 | 12.56 |
| Attributes 1 | PC1 | PC2 | PC3 | PC4 | PC5 | PC6 | PC7 | PC8 | PC9 | PC10 |
|---|---|---|---|---|---|---|---|---|---|---|
| MC | 14.53 | 3.90 | 0.03 | 5.05 | 0.05 | 41.68 | 34.56 | 0.12 | 0.04 | 0.00 |
| TSS | 10.34 | 5.61 | 5.75 | 28.96 | 13.94 | 3.21 | 7.10 | 0.51 | 24.38 | 0.15 |
| TTA | 10.14 | 7.94 | 1.81 | 17.74 | 37.64 | 2.00 | 0.02 | 2.82 | 19.76 | 0.10 |
| TSS/TTA | 14.42 | 12.04 | 5.70 | 1.26 | 3.86 | 1.67 | 9.95 | 2.83 | 48.01 | 0.22 |
| TA | 16.00 | 4.65 | 6.91 | 9.02 | 2.56 | 2.96 | 7.84 | 46.39 | 3.37 | 0.25 |
| TF | 16.28 | 5.66 | 5.85 | 4.23 | 4.43 | 5.15 | 9.10 | 47.07 | 2.06 | 0.12 |
| TPO | 15.04 | 2.33 | 1.71 | 0.96 | 5.82 | 41.71 | 30.83 | 0.00 | 1.57 | 0.00 |
| TP | 1.45 | 31.54 | 12.66 | 3.50 | 5.99 | 0.03 | 0.00 | 0.01 | 0.21 | 44.56 |
| TNF | 0.53 | 17.38 | 37.57 | 1.04 | 0.05 | 0.46 | 0.09 | 0.18 | 0.21 | 42.43 |
| AFFM | 1.22 | 8.91 | 21.97 | 28.20 | 25.61 | 1.08 | 0.46 | 0.04 | 0.34 | 12.12 |
| λi | 1.98 | 1.46 | 1.25 | 0.93 | 0.79 | 0.63 | 0.61 | 0.23 | 0.09 | 0.02 |
| PV (%) | 39.32 | 21.34 | 15.85 | 8.70 | 6.28 | 4.09 | 3.75 | 0.54 | 0.08 | 0.00 |
| APV (%) | 39.32 | 60.66 | 76.52 | 85.23 | 91.51 | 95.60 | 99.36 | 99.90 | 99.99 | 100.00 |
Disclaimer/Publisher’s Note: The statements, opinions and data contained in all publications are solely those of the individual author(s) and contributor(s) and not of MDPI and/or the editor(s). MDPI and/or the editor(s) disclaim responsibility for any injury to people or property resulting from any ideas, methods, instructions or products referred to in the content. |
© 2026 by the authors. Licensee MDPI, Basel, Switzerland. This article is an open access article distributed under the terms and conditions of the Creative Commons Attribution (CC BY) license.
Share and Cite
Chiomento, J.L.T.; Mandelli, N.A.; Ely, A.J.S.; Welter, M.; Didó, H.; Oliveira, M.A.L.; Jirkowski, B.; Reichert Junior, F.W.; Bortoluzzi, M.P.; Rieder, R.; et al. Microbial Biostimulants and Their Combinations Alter Phytochemical Quality of Strawberry Fruits in a Soilless Cultivation System. Horticulturae 2026, 12, 56. https://doi.org/10.3390/horticulturae12010056
Chiomento JLT, Mandelli NA, Ely AJS, Welter M, Didó H, Oliveira MAL, Jirkowski B, Reichert Junior FW, Bortoluzzi MP, Rieder R, et al. Microbial Biostimulants and Their Combinations Alter Phytochemical Quality of Strawberry Fruits in a Soilless Cultivation System. Horticulturae. 2026; 12(1):56. https://doi.org/10.3390/horticulturae12010056
Chicago/Turabian StyleChiomento, José Luís Trevizan, Nícolas Alberton Mandelli, Ana Júlia Schroeder Ely, Matheus Welter, Henrique Didó, Maria Antônia Lacourt Oliveira, Bruna Jirkowski, Francisco Wilson Reichert Junior, Mateus Possebon Bortoluzzi, Rafael Rieder, and et al. 2026. "Microbial Biostimulants and Their Combinations Alter Phytochemical Quality of Strawberry Fruits in a Soilless Cultivation System" Horticulturae 12, no. 1: 56. https://doi.org/10.3390/horticulturae12010056
APA StyleChiomento, J. L. T., Mandelli, N. A., Ely, A. J. S., Welter, M., Didó, H., Oliveira, M. A. L., Jirkowski, B., Reichert Junior, F. W., Bortoluzzi, M. P., Rieder, R., Trentin, T. d. S., & Sønsteby, A. (2026). Microbial Biostimulants and Their Combinations Alter Phytochemical Quality of Strawberry Fruits in a Soilless Cultivation System. Horticulturae, 12(1), 56. https://doi.org/10.3390/horticulturae12010056








